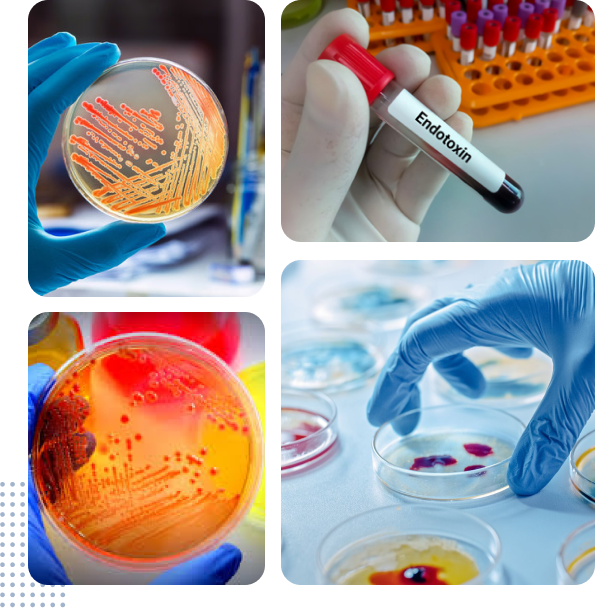

IBBPS’s Pharmaceutical Testing Laboratory holds ISO 17025 accreditation from PNAC. It boasts cutting-edge technologies and operates in accordance with guidelines from WHO, FDA, ICH, and GMP standards.
To request a test please download the form by clicking the button below and send to bd.ibbps@duhs.edu.pk.
Sections
The Pharmaceutical lab comprises of following sections:
- Sample Receipt Desk.
- Sample Preparation Area
- Wet Chemistry Lab
- Instrumentation Lab
- Chemical Storage Room
- Reference Standard Storage Room

Technologies
Following state-of-the-art technologies are available at the Pharmaceutical Lab:
- Atomic Absorption
- Gas Chromatography Mass-Spectrometry (GCMS)
- High-Performance Liquid Chromatography (HPLC)
- Liquid chromatography-mass spectrometry (LCMS-MS)
- UV Spectrophotometry
- Flame Photometry
- Infrared (IR) Spectrometry
- Karl Fischer Moisture Analysis
- Enzyme-Linked Immunosorbent Assay – ELISA

Microbiology services
Following state-of-the-art microbiology services are available at the Pharmaceutical Lab:
-
Anti-viral test, Bacterial endotoxin test
-
Toxin Test, Sterility Testing
-
Particulate count
-
Microbial Parameters as per USP
-
Microbial Parameters as per EP.
Rate List for IBBPS Tests
| IBBPS Lab Testing Rates Updated 2026 | ||
|---|---|---|
| S No. | Test | Rates (PKR) |
| Pharmaceutical Drug Testing | ||
| 1 | Dissolution test (Analysis by UV Spectrophotometer) | 20,250 |
| 2 | Dissolution test (Analysis by UV Spectrophotometer Slow Release) | 60,000 |
| 3 | Dissolution test (Analysis by HPLC) | 37,500 |
| 4 | Dissolution test (Analysis by HPLC Slow Release) | 60,000 |
| 5 | Comparative Dissolution Profile | 90,000 |
| 6 | Multi-Media Dissolution Profile | 100,000 |
| 7 | Biowaiver Preparation | 472,500 |
| 8 | Bio-Analytical Method Development & Validation | 500,000 |
| 9 | Analytical Method Verification | 378,000 |
| 10 | Analytical Method Validation | 472,500 |
| 11 | Drug Assay (HPLC) | 27,000 |
| 12 | Drug Assay (LCMS) | 30,000 |
| 13 | Disintegration Test | 7,425 |
| 14 | Friability test | 7,425 |
| 15 | Hardness test | 7,425 |
| 16 | Moisture Content/Loss on Drying | 16,200 |
| 17 | Uniformity of Dosage Unit by L1 criteria | 30,000 |
| 18 | Uniformity of Dosage Unit by Weight variation | 25,000 |
| 19 | Identification Test | 18,500 |
| 20 | Weight variation | 10,000 |
| 21 | Bioanalysis (Drug Assay) | 20,000 / sample |
| 22 | Appearance | 6,750 |
| Impurity Testing | ||
| 24 | Ethylene Glycol (Glycerin) | 37,900 |
| 25 | Di-Ethylene Glycol | 37,900 |
| 26 | NDMA Impurity | 128,250 |
| 27 | NDEA Impurity | 128,250 |
| 28 | NMBA Impurity | 128,250 |
| 29 | NIPEA Impurity | 128,250 |
| 30 | NMPA Impurity | 128,250 |
| 31 | NDIPA Impurity | 128,250 |
| 32 | Residual solvent (G.C) | 90,200 |
| Microbiology Testing | ||
| 33 | Anti-viral Activity Test | 40,000 |
| 34 | Bacterial Endotoxin Test | 30,000 |
| 35 | Toxin Test (Afflatoxin. Ochratoxin, T2 Toxin and Zearalenone) | 30,000 |
| 36 | Sterility Testing | 30,000 |
| 37 | Environmental Monitoring Test Per Plate | 10,000 |
| 38 | Anti-bacterial Activity Test | 20,000 |
| 39 | Bio-Burden Test (Fungus) | 20,000 |
| 40 | Bio-Burden Test (Bacteria) | 20,000 |
| 41 | Halal Test : b PCR reaction | 10,000 |
| 42 | Halal test : a (DNA Extraction) | |
| 43 | Particulate Count | 15,000 |
| 44 | Microbial Parameters USP | |
| 45 | Total Yeast & Mold Count | 18,000 |
| 46 | Staphylococcus aureus | |
| 47 | Salmonella | |
| 48 | Escherichia coli | |
| 49 | Pseudomonas aeruginosa | |
| 50 | Total Aerobic Microbial Count | |
| Microbial Parameters for Gelatin EP | 15,000 | |
| 51 | Total Yeast & Mold Count | |
| 52 | Total Aerobic Microbial Count | |
| 53 | Salmonella | |
| 54 | Escherichia coli | |
| Heavy metal | ||
| 55 | Heavy metal by Kits method (Lead, Chromium, Cadmium, Arsenic) | 5,000 |
| 56 | Heavy metal by Atomic Absorption | 75,000 |
| Steroid Testing | ||
| 57 | Cortisone | 10,600 |
| 58 | Hydrocortisone | 10,600 |
| 59 | Prednisolone | 10,600 |
| 60 | Dexamethasone | 10,600 |
| Iodine Testing | ||
| 61 | Detection of Iodine in table salts | 5,500 |
| 62 | Density | 7,425 |
| 64 | pH | 2,970 |
| 86 | TDS/ Conductivity | 3,900 |
Contact us
Contact Us
INSTITUTE OF BIOLOGICAL, BIOCHEMICAL & PHARMACEUTICAL SCIENCES (IBBPS)
